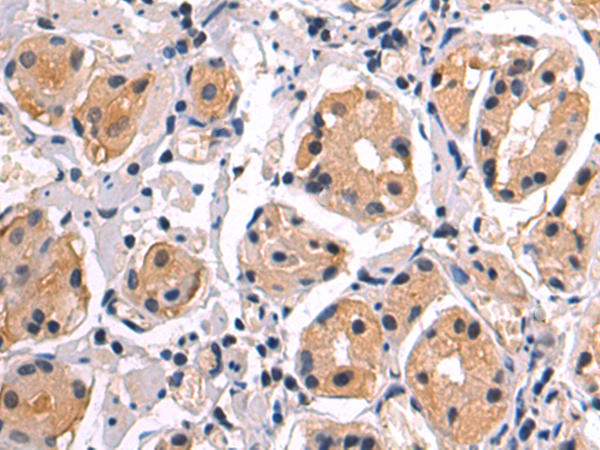

-
分类: 科研抗体货号: P11596别名: WBS; DIWS; SPIN; IB291; BAP135; BTKAP1; TFII-I; WBSCR6; GTFII-I应用: WB,IHC反应种属: Human, Mouse, Rat
-
分类: 科研抗体货号: P11594别名: BAI2应用: IHC反应种属: Human, Mouse
-
分类: 科研抗体货号: P11612别名: ik3-2; C20orf150; dJ908M14.2应用: IHC反应种属: Human, Mouse
-
分类: 科研抗体货号: P11593别名: BAI1; GDAIF应用: IHC反应种属: Human, Mouse, Rat
-
分类: 科研抗体货号: P11599别名: BAL; FAP; BSDL; BSSL; CELL; FAPP; LIPA; CEase; MODY8应用: WB,IHC反应种属: Human, Mouse
-
分类: 科研抗体货号: P11611别名: CBL2; NSLL; C-CBL; RNF55; FRA11B应用: WB反应种属: Human, Mouse
-
分类: 科研抗体货号: P11592别名: B7; BB1; B7-1; B7.1; LAB7; CD28LG; CD28LG1应用: IHC反应种属: Human
-
分类: 科研抗体货号: P11598别名: OC; BGP; OCN应用: IHC反应种属: Human
-
分类: 科研抗体货号: P11609别名: CD157应用: IHC反应种属: Human, Mouse, Rat
-
分类: 科研抗体货号: P11591别名: efg; Cmyb; c-myb; c-myb_CDS应用: WB反应种属: Human, Mouse

鄂公网安备42018502007531号
鄂公网安备42018502007531号

